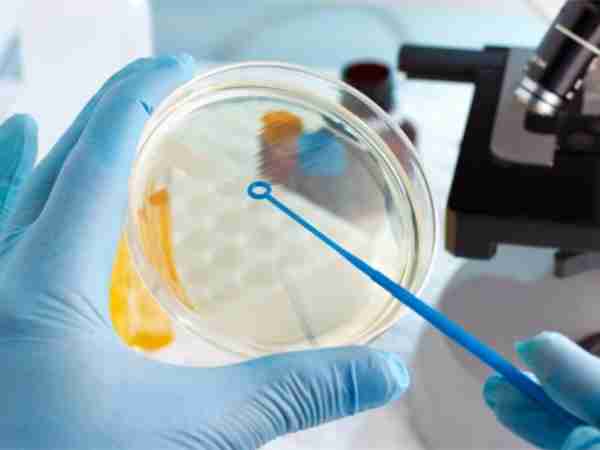
试管爸爸国际助孕中心合作医院-美国生殖医疗中心AFMC

美国生殖医疗中心AFMC
美国生殖医疗中心AFMC是加州最大的生殖医疗中心之一,也是美国病理学家协会(CAP)最高级别认证的国际顶级综合生殖中心。该院凭着高超的技术和一流的设备,卓越的成功率,成为行业中的佼佼者,目前试管婴儿成功率达70%~75%,且中心的试管医生都是全美知名生殖医学专家、胚胎师和基因学家。
美国AFMC生殖医疗中心介绍
Amcertcan Fertility Medical Center美国生殖医学中心,对外简称AFMC,成立时间1970年01月,是一家坐落于美国西海岸中心城市洛杉矶的专业生殖医疗、临床和科研
机构,有享誉国际的知名生殖专家,美国加州大学洛杉矶分校医学院妇产科及辅助生殖医学中心教授、ucla医疗教学管理医院生殖试管中心主任Dr. Jackson Wu联合加
州知名医生、胚胎学专家、医疗科学家以及基因实验室专家创立而成。
AFMC总占地面积超过12000平方英尺,专门为生殖辅助医疗服务设计建造了世界一流的胚胎实验室、基因实验室、精液分析室。拥有目前生殖医疗行业最成熟、最先进
的技术。AFMC胚胎学和基因学家秉承对生殖医学至臻追求和敬业精神,致力于为每一位准父母提供全方位和最贴心的一站式辅助生殖生育服务,AFMC将以个性化的治
疗方案和卓越的成功率,回馈您对我们的信任和期望,用专业和爱心搭建幸福的桥梁。

团队有享誉国际的知名生殖专家、美国加州大学洛杉矶分校终身教授,UCLA医疗教学管理医院生殖试管中心主任的Dr.Tacksom Wu,联合加州生殖医生,胚胎学专家以
及基因,实验室专家创立而成,平均从业年龄30年以上。
医院服务
1、完善的客户服务体系,严格控制就诊病人数量,确保每一位客户都能享受到个性化的医生全程亲诊医疗服务;
2、临床及服务团队均配置经验丰富的中英文协调员,为您提供贴心舒适的一对一孕育体验。
医院实验室
1、实验室是一家生殖中心核心的技术体现,AFMC拥有世界流的胚胎实验室和精液分析室,代表目前成熟和前沿的技术;
2、生殖细胞的冷冻储存、解冻以及卵子精子受精过程全靠实验室的技术设备和胚胎专家的专业操作来实现,保证了不会对细胞组织造成任何伤害;
3、AFMC有全球恒温箱模拟人体子宫环境,它对温度、湿度、氧气浓度等方面都有极高的要求,可以更好的支撑胚胎发育到第五天的囊胚阶段。
AMFC同时是全球为数不多的拥有自己的基因检测实验室的专业生殖医疗机构。胚胎实验室获得了由重量及国际权威实验室认证机构所颁发的CL IA(Certificate of
Accreditation)和美国食品药品监督局(FDA),双重最高级别的认证。
成功率
70%-75%
支持技术
第三代试管婴儿、胚胎冷冻、IVF/ICSI、供卵、供精、单身/同性助孕
医院位置

1370 Valley Vista Dr,Unit 135 ,Diamond Bar ,CA 91765
如果你想要了解多国辅助生殖方案的更多内容,也可以联系美国AFMC生殖医疗中心专业客服免费咨询。客服电话:13880857038